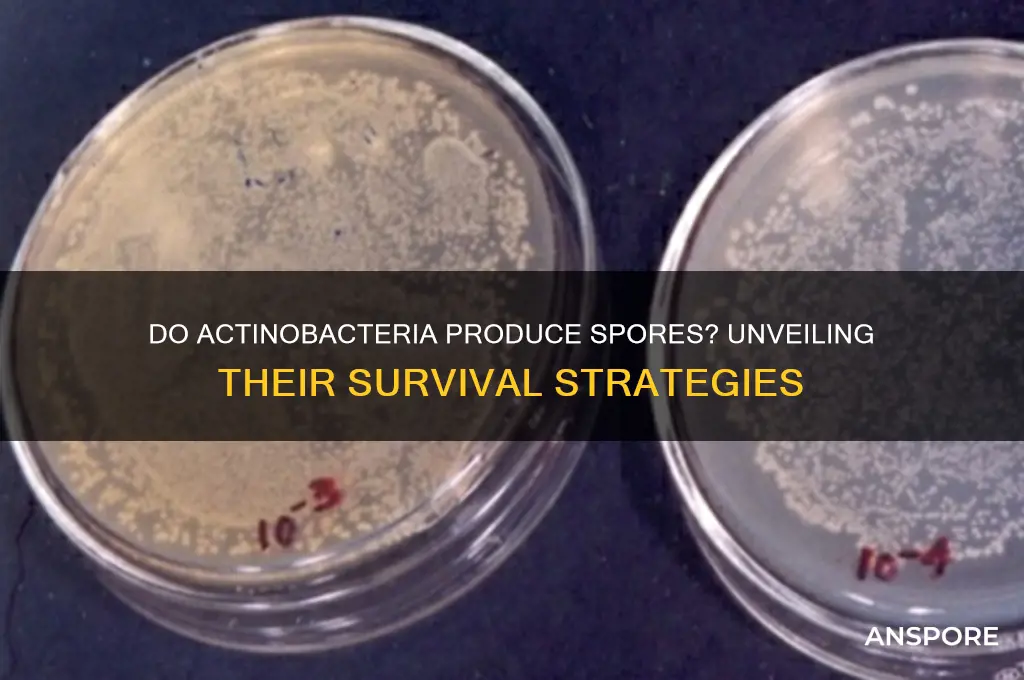
can actinobacteria form spores

Actinobacteria, a diverse group of Gram-positive bacteria, are known for their filamentous growth and significant roles in soil ecology, biotechnology, and medicine. One intriguing aspect of their biology is their ability to form spores, a characteristic that enhances their survival in harsh environmental conditions. While not all Actinobacteria produce spores, certain genera, such as *Streptomyces* and *Streptosporangium*, are well-documented for their sporulation capabilities. These spores are highly resistant to desiccation, heat, and chemicals, allowing Actinobacteria to persist in diverse habitats. The process of sporulation in Actinobacteria involves complex morphological and biochemical changes, distinct from that of other spore-forming bacteria like *Bacillus*. Understanding their sporulation mechanisms not only sheds light on their ecological resilience but also has implications for biotechnological applications, such as the production of antibiotics and enzymes.
| Characteristics | Values |
|---|---|
| Can Actinobacteria form spores? | Yes, some species of Actinobacteria can form spores. |
| Type of spores | Endospores (in some species like Streptomyces) |
| Function of spores | Survival in harsh conditions (e.g., heat, desiccation, chemicals) |
| Sporulation process | Complex, involving multiple stages and specialized structures (e.g., sporangia in Streptomyces) |
| Examples of spore-forming Actinobacteria | Streptomyces, Actinomyces, Nocardia (some species) |
| Non-spore-forming Actinobacteria | Mycobacterium, Corynebacterium (most species) |
| Ecological significance | Spores aid in dispersal and long-term survival in diverse environments |
| Medical relevance | Spores can contribute to antibiotic resistance and persistence in infections |
| Industrial applications | Spore-forming Actinobacteria are used in biotechnology for antibiotic production |
| Taxonomic diversity | Sporulation is not universal; varies across Actinobacteria genera and species |
Explore related products
What You'll Learn
- Sporulation Mechanisms: How actinobacteria initiate and complete the spore formation process under stress
- Environmental Triggers: Factors like nutrient depletion or pH changes inducing spore development
- Spore Structure: Unique morphological and biochemical features of actinobacterial spores
- Survival Advantages: How spores enhance actinobacteria's longevity in harsh conditions
- Species Variability: Differences in spore-forming abilities among actinobacterial genera

Sporulation Mechanisms: How actinobacteria initiate and complete the spore formation process under stress
Actinobacteria, a diverse group of Gram-positive bacteria, are renowned for their ability to produce a wide array of bioactive compounds, including antibiotics. Among their survival strategies, sporulation stands out as a critical mechanism to endure harsh environmental conditions. Unlike the well-studied *Bacillus* and *Clostridium* species, actinobacterial sporulation is less understood but equally fascinating. When faced with stressors such as nutrient depletion, desiccation, or extreme temperatures, certain actinobacteria, like *Streptomyces*, initiate a complex process to form spores, ensuring long-term survival.
The sporulation process in actinobacteria begins with the detection of stress signals, which trigger a cascade of genetic and biochemical events. For instance, in *Streptomyces*, the *whi* (sporulation inhibition) and *ssd* (sporulation-specific DNA-binding proteins) genes play pivotal roles in regulating the transition from vegetative growth to spore formation. These genes activate the production of sigma factors, such as σ^F and σ^H, which direct the transcription of sporulation-specific genes. This regulatory network ensures that spore formation is tightly controlled and only occurs under appropriate conditions.
Once the decision to sporulate is made, actinobacteria undergo a series of morphological changes. The cell divides asymmetrically, forming a compartmentalized structure where the spore develops. This process involves the synthesis of a thick, protective spore wall composed of peptidoglycan and specialized lipids, which confer resistance to heat, UV radiation, and desiccation. For example, *Streptomyces* spores contain a unique lipid, diphosphatidylglycerol, which enhances their stability. Concurrently, the cell dehydrates, and the DNA is compacted and protected by proteins like small acid-soluble spore proteins (SASPs), ensuring genetic integrity during dormancy.
Practical applications of actinobacterial sporulation are vast, particularly in biotechnology and agriculture. Understanding these mechanisms can improve the production of secondary metabolites, as many antibiotics are synthesized during the transition to sporulation. For instance, optimizing growth conditions to mimic stress-induced sporulation can enhance the yield of bioactive compounds. Additionally, actinobacterial spores can be used as bioinoculants to improve soil health, as their resilience allows them to survive and thrive in diverse environments, promoting plant growth and suppressing pathogens.
In conclusion, the sporulation mechanisms of actinobacteria are a testament to their adaptability and resilience. By deciphering the genetic and biochemical pathways involved, scientists can harness this process for biotechnological advancements and sustainable agricultural practices. Whether in the lab or the field, actinobacterial spores offer a wealth of opportunities for innovation and application.
Can Fungi Reproduce Without Spores? Exploring Alternative Reproduction Methods
You may want to see also

Environmental Triggers: Factors like nutrient depletion or pH changes inducing spore development
Actinobacteria, a diverse group of gram-positive bacteria, are known for their ecological significance and biotechnological applications. While not all Actinobacteria form spores, certain genera, such as *Streptomyces*, are renowned for their ability to produce spores under specific conditions. Environmental triggers play a pivotal role in inducing spore development, acting as a survival mechanism in response to adverse conditions. Among these triggers, nutrient depletion and pH changes are particularly influential, signaling the bacterium to transition from vegetative growth to a dormant, resilient state.
Consider nutrient depletion, a common stressor in natural habitats. When essential resources like carbon, nitrogen, or phosphorus become scarce, Actinobacteria like *Streptomyces* initiate a cascade of physiological changes. For instance, studies have shown that reducing the concentration of glucose in the growth medium from 1% to 0.1% can significantly accelerate spore formation in *Streptomyces coelicolor*. This response is not merely a passive reaction but a highly regulated process involving the activation of genes responsible for sporulation, such as the *bld* and *whi* gene clusters. Understanding this mechanism is crucial for optimizing spore production in biotechnological processes, where controlled nutrient limitation can be strategically employed to enhance yields.
PH changes represent another critical environmental trigger for spore development in Actinobacteria. These bacteria thrive in slightly acidic to neutral environments, typically within a pH range of 6.5 to 7.5. Deviations from this range, particularly toward more acidic or alkaline conditions, can induce sporulation as a protective measure. For example, exposing *Streptomyces griseus* to a pH shift from 7.0 to 5.5 has been observed to trigger spore formation within 24–48 hours. This pH-induced sporulation is mediated by alterations in membrane integrity and intracellular signaling pathways, highlighting the bacterium’s adaptability to environmental stress. Researchers and industrial practitioners can leverage this knowledge by manipulating pH levels to control spore production in fermentation processes.
A comparative analysis of nutrient depletion and pH changes reveals their distinct yet complementary roles in inducing spore development. While nutrient depletion primarily acts as a long-term stressor, prompting the bacterium to conserve resources, pH changes exert an immediate, acute stress that necessitates rapid response. Both triggers, however, converge on the activation of sporulation pathways, underscoring the robustness of Actinobacteria’s survival strategies. For instance, combining moderate nutrient limitation with a slight pH adjustment (e.g., reducing glucose to 0.2% and lowering pH to 6.0) has been shown to synergistically enhance spore yields in *Streptomyces avermitilis*, a key producer of avermectin.
Practical applications of these environmental triggers extend beyond laboratory settings. In agriculture, for example, understanding how soil pH and nutrient availability influence Actinobacterial sporulation can inform strategies for enhancing soil health and biocontrol. Farmers can amend soils with organic matter to maintain optimal nutrient levels and pH, thereby promoting the growth and sporulation of beneficial Actinobacteria. Similarly, in pharmaceutical production, precise control of these factors can maximize the yield of bioactive compounds derived from Actinobacterial spores. By harnessing the power of environmental triggers, we can unlock the full potential of Actinobacteria in both natural and industrial contexts.
Can Spores or Pollen Survive in Distilled Water? Exploring the Science
You may want to see also

Spore Structure: Unique morphological and biochemical features of actinobacterial spores
Actinobacteria, a diverse group of Gram-positive bacteria, are renowned for their ability to produce spores under adverse environmental conditions. These spores are not merely survival mechanisms but exhibit unique morphological and biochemical features that distinguish them from those of other spore-forming bacteria, such as *Bacillus*. Understanding these features is crucial for identifying actinobacterial spores in environmental samples, clinical isolates, and biotechnological applications.
Morphologically, actinobacterial spores are often smaller and more irregular in shape compared to the uniform, oval spores of *Bacillus*. For instance, *Streptomyces* spores are typically filamentous and borne on specialized structures called sporophores, which are absent in other spore-forming bacteria. This distinctive arrangement allows for efficient spore dispersal in soil environments, where *Streptomyces* species predominantly reside. Additionally, actinobacterial spores lack the thick, multi-layered cortex found in *Bacillus* spores, instead possessing a simpler, single-layered structure. This difference influences their resistance to heat, desiccation, and chemicals, making them less resilient but more adaptable to specific ecological niches.
Biochemically, actinobacterial spores are characterized by unique cell wall components, such as mycolic acids, which are also found in their vegetative cells. Mycolic acids contribute to the spore’s hydrophobicity and structural integrity, enhancing survival in soil and water environments. Another notable feature is the presence of dipicolinic acid (DPA), a universal marker for bacterial spores. However, actinobacterial spores contain significantly lower DPA levels compared to *Bacillus* spores, typically ranging from 5% to 10% of their dry weight. This lower DPA concentration correlates with their reduced heat resistance but may play a role in rapid germination under favorable conditions.
Practical identification of actinobacterial spores can be achieved through staining techniques, such as the Schaeffer-Fulton stain, which differentiates spores from vegetative cells. However, distinguishing actinobacterial spores from those of other genera requires additional methods, such as electron microscopy to observe sporophore structures or molecular techniques like PCR targeting spore-specific genes. For researchers and biotechnologists, understanding these unique features is essential for optimizing spore production in actinobacteria, which are valuable sources of antibiotics, enzymes, and bioactive compounds.
In summary, actinobacterial spores exhibit a combination of morphological and biochemical traits that set them apart from other bacterial spores. Their smaller size, irregular shape, mycolic acid-rich cell walls, and lower DPA content reflect adaptations to specific ecological roles. By focusing on these unique features, scientists can better harness the potential of actinobacterial spores in environmental studies, medicine, and industry.
Are Wet Rot Spores Ariborane? Unraveling the Fungal Mystery
You may want to see also
Explore related products

Survival Advantages: How spores enhance actinobacteria's longevity in harsh conditions
Actinobacteria, a diverse group of gram-positive bacteria, are renowned for their ability to produce a wide array of bioactive compounds, including antibiotics. Among their survival strategies, spore formation stands out as a critical mechanism for enduring harsh environmental conditions. Unlike many other bacteria, not all actinobacteria form spores, but those that do, such as *Streptomyces*, gain significant survival advantages. Spores are highly resistant structures that enable these organisms to withstand extreme temperatures, desiccation, and exposure to chemicals, ensuring their longevity in environments that would otherwise be lethal.
Consider the lifecycle of *Streptomyces*, a well-studied actinobacterium. When nutrients become scarce, it undergoes sporulation, a process where vegetative cells differentiate into dormant spores. These spores have a robust outer coating composed of peptidoglycan and keratin-like proteins, providing a protective barrier against physical and chemical stressors. For instance, spores can survive temperatures ranging from -20°C to 80°C, making them resilient in both freezing and scorching environments. This adaptability is particularly crucial in soil ecosystems, where actinobacteria play a vital role in nutrient cycling and organic matter decomposition.
The survival advantages of spores extend beyond physical protection. Spores remain metabolically inactive, reducing energy expenditure and conserving resources until conditions improve. This dormancy can last for years, allowing actinobacteria to persist in nutrient-depleted soils or arid regions. For example, in deserts, where water is scarce and temperatures fluctuate drastically, spore-forming actinobacteria can remain viable, waiting for rare rainfall events to reactivate their metabolic processes. This strategy ensures their continued presence in ecosystems where other microorganisms might perish.
From a practical standpoint, understanding spore formation in actinobacteria has significant implications for biotechnology and agriculture. Spores can be harnessed for the production of bioactive compounds, as they often contain the genetic machinery for synthesizing antibiotics and other secondary metabolites. Additionally, spore-forming actinobacteria can be used as bioinoculants to enhance soil health, particularly in degraded or nutrient-poor environments. For optimal results, apply spore-based inoculants at a rate of 10^6 to 10^8 spores per gram of soil, ensuring even distribution for maximum efficacy.
In conclusion, spore formation is a key survival mechanism that enhances the longevity of actinobacteria in harsh conditions. By encapsulating their genetic material in a protective shell, these organisms can endure extreme temperatures, desiccation, and chemical exposure. This adaptability not only ensures their survival but also positions them as valuable resources for biotechnological applications. Whether in natural ecosystems or agricultural settings, the ability of actinobacteria to form spores underscores their resilience and utility in challenging environments.
Mastering Jungle Spore Collection: Essential Tips and Techniques Revealed
You may want to see also

Species Variability: Differences in spore-forming abilities among actinobacterial genera
Actinobacteria, a diverse phylum of Gram-positive bacteria, exhibit remarkable variability in their spore-forming abilities. While some genera, such as *Streptomyces*, are renowned for their prolific sporulation, others like *Mycobacterium* lack this capability entirely. This disparity underscores the importance of understanding species-specific traits within the phylum. For instance, *Streptomyces* species produce chains of spores (conidia) as a survival mechanism in adverse conditions, whereas *Corynebacterium* species, despite being closely related, do not form spores. This variability is not random but reflects evolutionary adaptations to distinct ecological niches, such as soil, water, or host environments.
To explore this further, consider the sporulation process in *Streptomyces*, which involves a complex developmental cycle triggered by nutrient depletion. This genus employs spores as a means of dispersal and long-term survival, making it a dominant player in soil ecosystems. In contrast, *Mycobacterium*, including the tuberculosis-causing *M. tuberculosis*, relies on other mechanisms like cell wall modifications for persistence. This difference is critical in clinical settings, as spore formation is often associated with antibiotic resistance and environmental resilience. For researchers, identifying spore-forming capabilities can guide the development of targeted treatments or biocontrol agents, particularly in agriculture where *Streptomyces* spores are harnessed for their antifungal properties.
A comparative analysis of spore-forming and non-spore-forming actinobacteria reveals distinct metabolic and genetic underpinnings. Spore-formers typically possess larger genomes with genes dedicated to sporulation, such as those encoding sigma factors and sporulation-specific proteins. For example, *Streptomyces coelicolor* has a genome size of ~8.7 Mb, significantly larger than the ~4.4 Mb genome of *Mycobacterium smegmatis*. This genetic disparity highlights the evolutionary trade-offs between investing in spore formation versus other survival strategies. Practitioners in biotechnology can leverage this knowledge to engineer spore-forming strains for enhanced stability in industrial processes, such as enzyme production or bioactive compound synthesis.
Practical applications of this species variability are evident in environmental remediation and medicine. Spore-forming actinobacteria like *Streptomyces* are used in bioremediation to degrade pollutants, as their spores can withstand harsh conditions before activating to metabolize contaminants. Conversely, understanding why *Mycobacterium* does not form spores aids in developing strategies to combat mycobacterial infections, where persistence rather than sporulation is the challenge. For instance, targeting non-replicating persister cells in *M. tuberculosis* requires different approaches than those used against spore-forming pathogens. This nuanced understanding of spore-forming abilities across genera is essential for both applied and fundamental research.
In conclusion, the variability in spore-forming abilities among actinobacterial genera is a key factor in their ecological roles and biotechnological potential. From *Streptomyces*’s spore-driven dominance in soil to *Mycobacterium*’s spore-free persistence in hosts, these differences reflect tailored evolutionary strategies. Researchers and practitioners can capitalize on this knowledge to optimize actinobacteria for specific applications, whether in agriculture, industry, or medicine. By focusing on species-specific traits, we unlock the full potential of this versatile phylum.
Inhaling Fungal Spores: Uncovering the Truth About Common Fungal Diseases
You may want to see also
Frequently asked questions
No, not all Actinobacteria can form spores. While many species, particularly those in the genus *Streptomyces*, are known for their ability to produce spores, others within the phylum do not have this capability.
Spore formation in Actinobacteria serves as a survival mechanism, allowing them to withstand harsh environmental conditions such as desiccation, extreme temperatures, and nutrient deprivation. Spores remain dormant until favorable conditions return.
Actinobacteria spores, particularly in *Streptomyces*, are unique in their structure and formation process. They are typically formed at the tips of aerial hyphae and are often characterized by a thick, resistant cell wall composed of specialized lipids and proteins.
Actinobacteria spores themselves are generally not infectious to humans. However, some Actinobacteria species, such as *Mycobacterium tuberculosis*, can cause disease, though their spores are not the primary mode of transmission.
Yes, Actinobacteria spores, especially from *Streptomyces*, are valuable in biotechnology for producing antibiotics, enzymes, and other bioactive compounds. Their ability to form spores also makes them useful in processes requiring long-term storage and stability.


















![Substances screened for ability to reduce thermal resistance of bacterial spores 1959 [Hardcover]](https://m.media-amazon.com/images/I/51Z99EgARVL._AC_UL320_.jpg)












